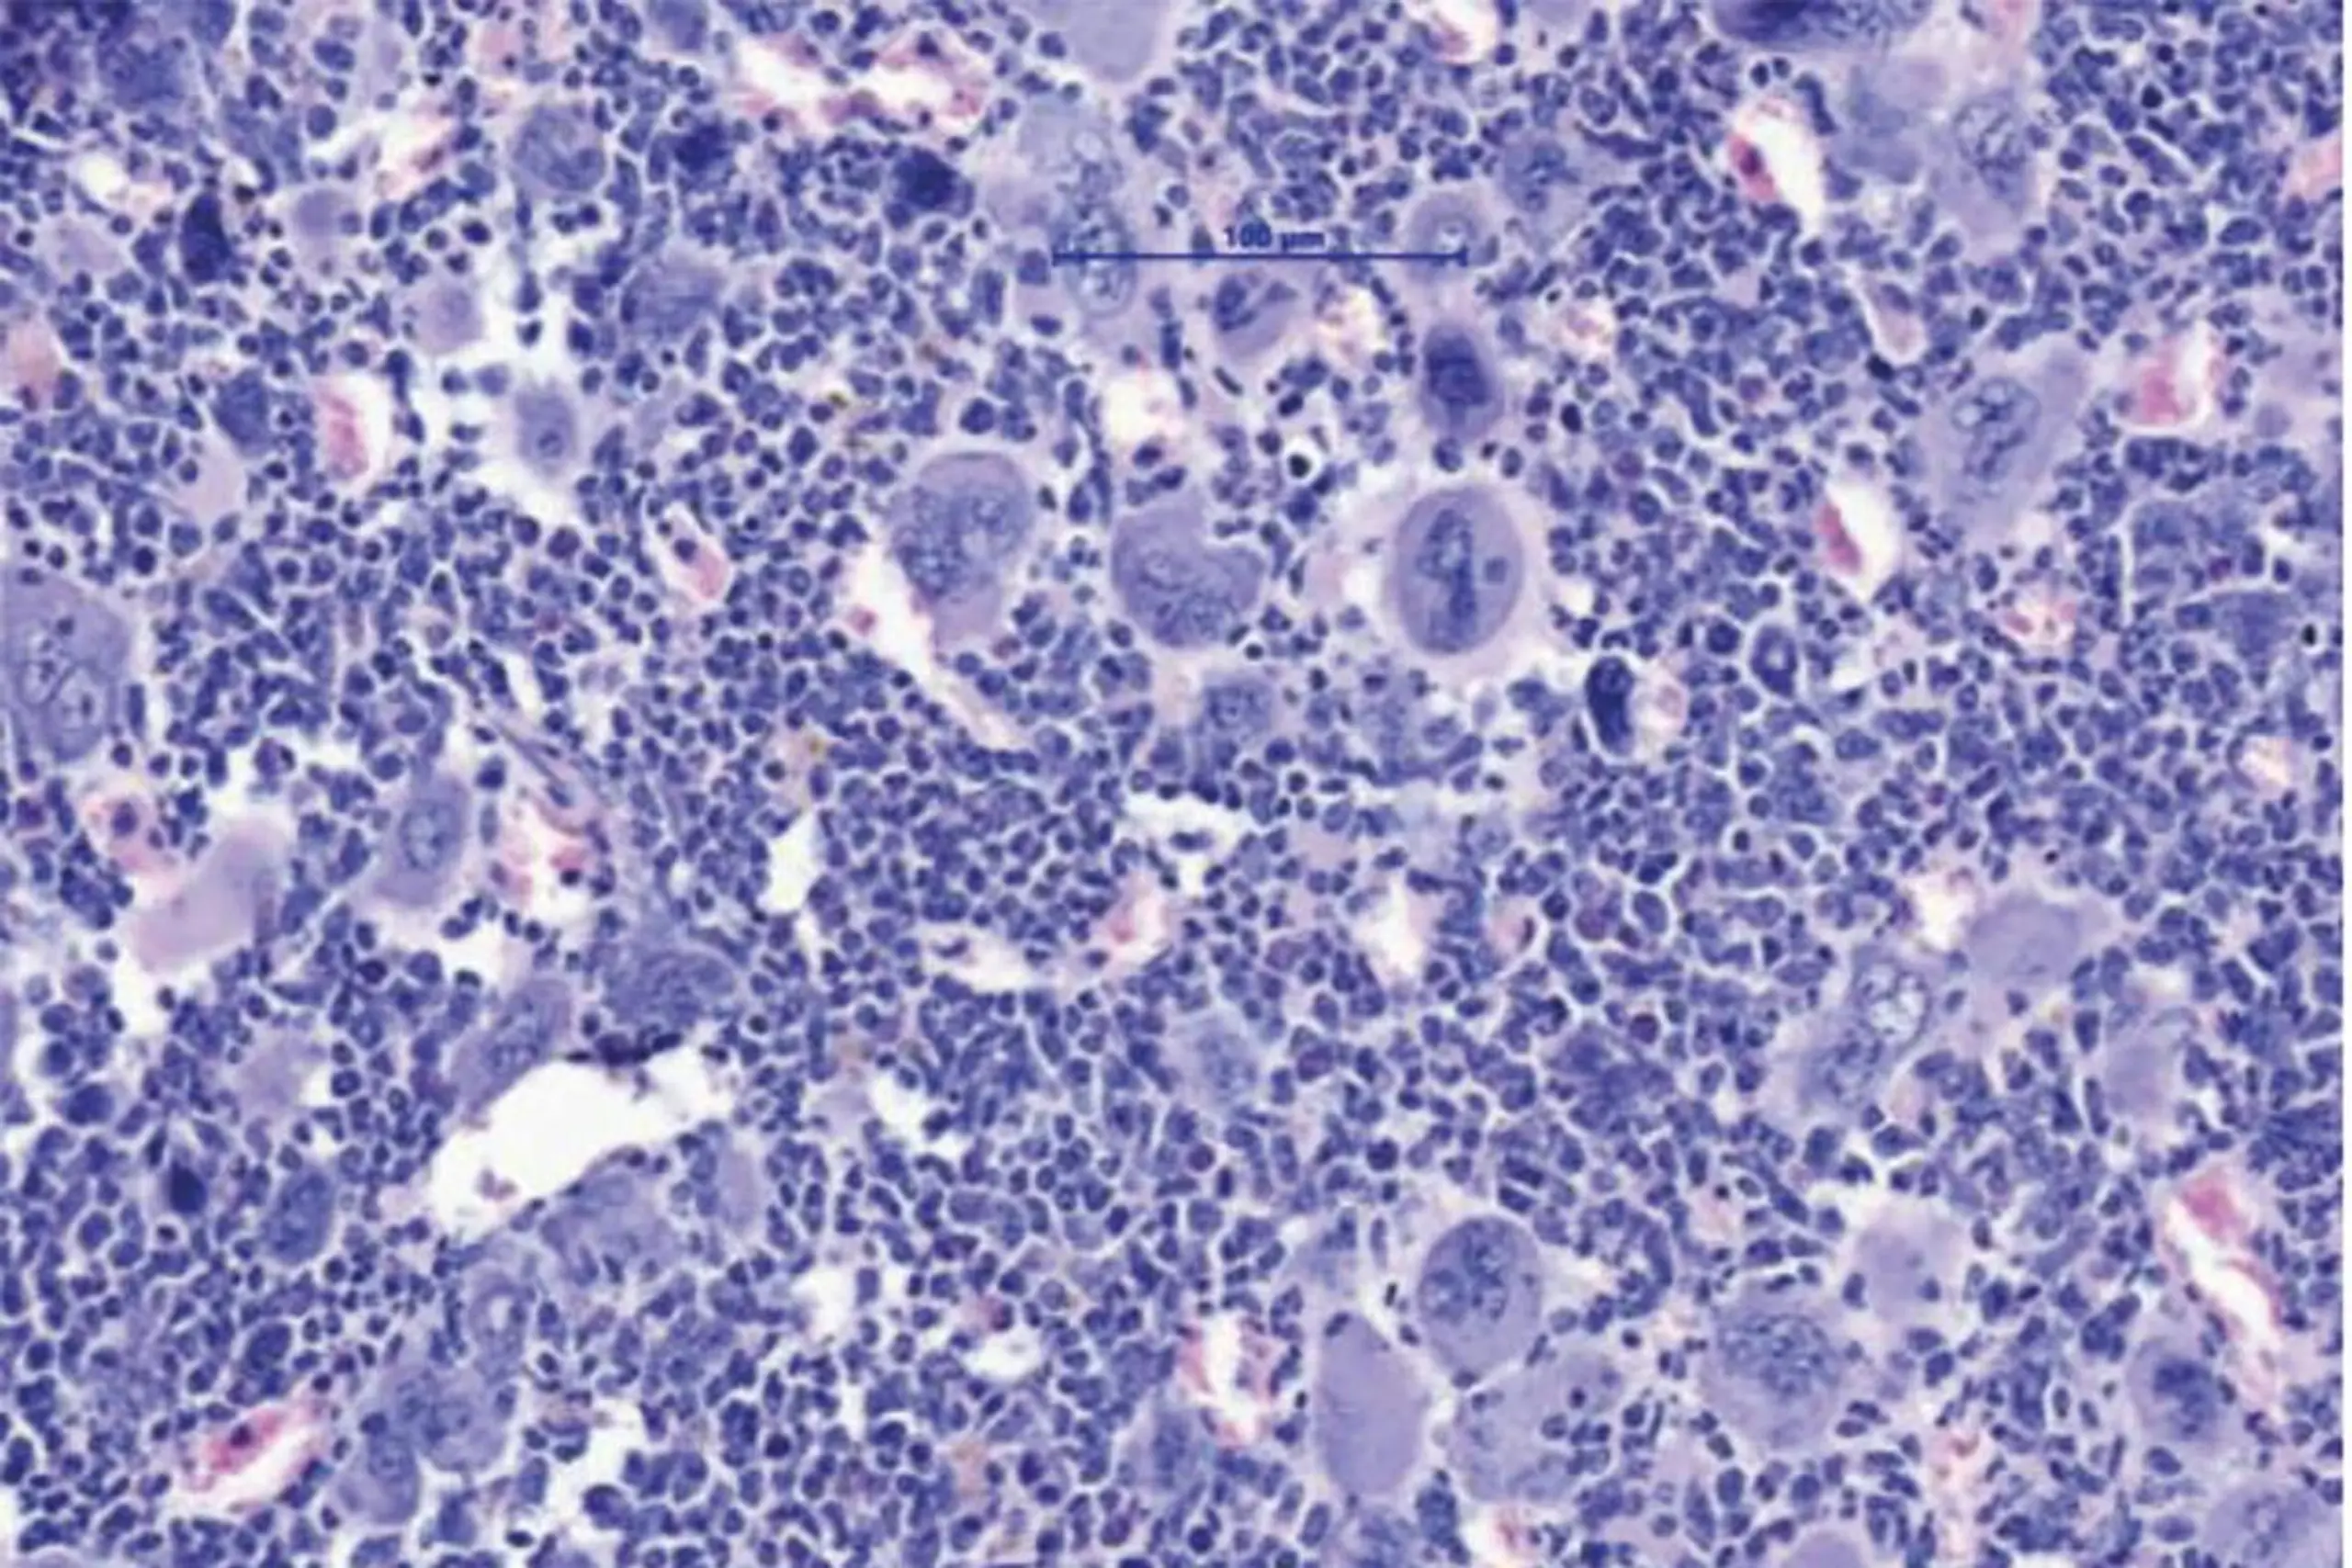
MPN sind durch eine Expansion des blutbildenden Systems im Knochenmark charakterisiert. Dies führt zum Anstieg verschiedener Zellreihen und im Endzustand dann zur Knochenmarksvernarbung und auch akuten Leukämie

von
"Wir brauchen dringend neue Therapiekonzepte", betonte Wolf, Direktor der Universitätsklinik für Innere Medizin V an der Med Uni, in einer Aussendung am Dienstag. Eine Stammzelltransplantation biete zwar die Chance auf Heilung, sei für viele Patientinnen und Patienten aufgrund hohen Alters oder Begleiterkrankungen jedoch mit zu großen Risiken verbunden. Man habe daher nach anderen Stellschrauben im Entzündungsgeschehen gesucht und sei auf NLRP3 als möglichen Angriffspunkt gestoßen, berichtete der Onkologe. Die Studie wurde im Fachjournal "Nature Communications" veröffentlicht.
Myeloproliferative Neoplasien, eine Gruppe von Blut- bzw. Knochenmarkerkrankungen, sind durch eine Überproduktion von Blutzellen gekennzeichnet, treten in der Regel ab einem Alter von etwa 60 Jahren auf und können über Jahre kontrolliert verlaufen, bevor es zu einer lebensbedrohlichen Vernarbung des Knochenmarks (Myelofibrose) und in manchen Fällen zur akuten Leukämie kommt. Ausgelöst werden die Entzündungsprozesse unter anderem durch die Treibermutation JAK2V617F, die sowohl bösartige als auch begleitende sowie noch gesunde Blutzellen betrifft.
Das NLRP3-Inflammasom fungiert als Sensor für Gefahrensignale im Körper und steuert Entzündungsreaktionen, die bereits bei Erkrankungen wie Atherosklerose, Gicht oder Diabetes Typ-2 untersucht wurden. In Kooperation mit der German Study Group of MPN (GSG-MPN) werteten Forscher der Universitätskliniken in Innsbruck und Bonn eine große Anzahl von Patientenproben aus und kartierten die Entzündungsreaktionen. Dabei wurde die Aktivierung von NLRP3 sowohl in Proben von Betroffenen als auch in einem MPN-Tiermodell nachgewiesen.
Durch die genetische Ausschaltung von NLRP3 in Knockout-Mäusen sowie den Einsatz eines neuartigen, spezifischen NLRP3-Inhibitors (IFM-2384) im Tiermodell erreichten die Wissenschafter eine Rückbildung der Knochenmarksvernarbung und eine Verringerung der meist ausgeprägten Milzvergrößerung. Gleichzeitig verbesserte sich das Blutbild der Tiere.
In einer vertiefenden Analyse zeigte sich, dass insbesondere die Überproduktion von Blutplättchen im Zuge der NLRP3-Blockade deutlich abnahm. "Das NLRP3-Inflammasom spielt eine große Rolle als Gefahrensensor", erläuterte Mitautor Lino Teichmann. Bei akutem Stress wie Infektionen werde ein Rescue-Mechanismus aktiviert, der rasch große Mengen an Blutplättchen erzeugt. Im komplexen Entzündungsgeschehen bei MPN scheine NLRP3 daher eine zentrale Funktion einzunehmen, fasste Wolf zusammen.
Die Innsbrucker Arbeitsgruppe erhielt erst vor wenigen Tagen ein HOPE-Projekt im Rahmen von EP PerMed zugesprochen. Gemeinsam mit Kolleginnen und Kollegen anderer Zentren in Österreich und Deutschland sollen die hochauflösende Kartierung von myeloproliferativen Neoplasien und die NLRP3-abhängigen Entzündungsmechanismen weiter vorangetrieben werden. Langfristig soll geprüft werden, inwieweit NLRP3-Hemmer in klinischen Studien eingesetzt werden können. Mit der Identifikation des NLRP3-Inflammasoms als zentralem Baustein der Entzündungsreaktion liegt zudem ein potenzielles neues Ziel für künftige Medikamente vor.
INNSBRUCK - ÖSTERREICH: FOTO: APA/MUI/Univ-Klinik für Innere Medizin V